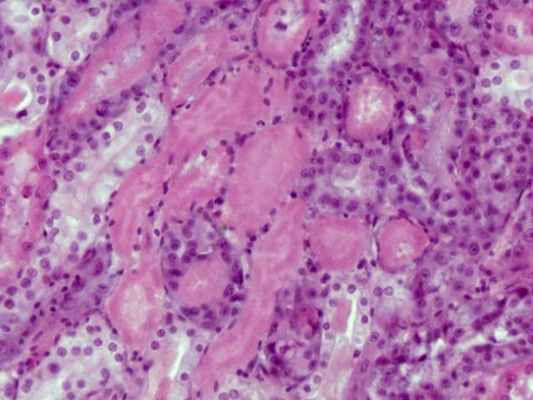

Волосатая лейкоплакия. Эритроплакия. Гемангиома. Саркома Капоши.
Добавил пользователь Дмитрий К. Обновлено: 27.01.2026
"OSMF" перенаправляется сюда. Для фундамента, который работает OpenStreetMap, видеть Фонд OpenStreetMap.
Подслизистый фиброз полости рта хроническое, сложное, предраковое (риск трансформации 1%) состояние полости рта, характеризующеесяэпителиальный воспалительная реакция и прогрессирующая фиброз подводной лодкислизистая оболочка ткани ( собственная пластинка и более глубокие соединительные ткани). По мере прогрессирования заболевания слизистая оболочка полости рта становится фиброзной до такой степени, что человек не может открыть рот. [1] [2] Состояние удаленно связано с рак полости рта и связан с орех ареки и / или жевание его побочных продуктов, в основном практикуемое в странах Южной и Юго-Восточной Азии. [3] Заболеваемость OSMF также увеличилась в западных странах из-за изменения привычек и постоянной миграции населения. [4]
Содержание
Определения
Пер Йенс Дж. Пиндборг и Сатьявати Ширсат (1966) (Патологическое определение) - «Коварное хроническое заболевание, поражающее любую часть ротовой полости, а иногда и глотку. Хотя иногда этому предшествует и / или связано с образованием везикул, оно всегда связано с воспалительной реакцией юкста-эпителия, за которой следует фиброэластическое изменение собственной пластинки с эпителиальной атрофией, приводящей к жесткости ». [5]
Пер Мохит Шарма и Рагху Радхакриснан (2019) - «Коварное хроническое потенциально злокачественное фиброзное заболевание, поражающее всю ротовую полость, а иногда и глотку и пищевод. Хотя иногда этому предшествует и / или связано с образованием везикул, оно всегда связано с воспалительной реакцией околосклеродного эпителия с последующим фиброэластическим изменением собственной пластинки с эпителиальной атрофией, приводящей к жесткости слизистой оболочки рта, прогрессирующему уменьшению открывания рта и неспособности есть' [6]
Пер Чандрамани Мор и Наман Рао (2019) (Клиническое определение) - «Изнурительное, прогрессирующее, необратимое нарушение метаболизма коллагена, вызванное хроническим жеванием ореха арека и его коммерческих препаратов; поражение слизистой оболочки полости рта и иногда глотки и пищевода; приводит к жесткости слизистых оболочек и нарушению функций; и имеет потенциальный риск злокачественной трансформации ». [7]
Эпидемиология
Заболеваемость болезнью выше у людей из определенных частей мира, включая Южную и Юго-Восточную Азию, Южная Африка и Ближневосточный страны. [8]
Симптомы
В начальной фазе заболевания слизистая оболочка ощущается кожистой с пальпируемыми фиброзными тяжами. На поздних стадиях слизистая оболочка полости рта теряет упругость, становится бледной и жесткой. Считается, что заболевание начинается в задней части ротовой полости и постепенно распространяется наружу.
К другим особенностям болезни можно отнести:
- Ксеростомия
- Рецидивирующее изъязвление
- Боль в ухе или глухота
- Носовая интонация голоса
- Ограничение движения мягкого неба
- Бутоноподобный сморщенный язычок
- Истончение и жесткость губ
- Пигментация слизистой оболочки рта
- Сухость во рту и чувство жжения (стоматопироз)
- Уменьшение открывания рта и выпячивания языка
Причины
Сушеные продукты, такие как паан масала и гутха иметь более высокую концентрацию орех ареки и, кажется, вызывает болезнь. Другие причины включают:
- Иммунологические заболевания
- Экстремальные климатические условия
- Длительный дефицит железа и витаминов в рационе
Патогенез
«В настоящее время считается, что воздействие продуктов, содержащих орех арека (Arecacatechu) с табаком или без него (ANCP / T), приводит к OSF у людей с генетической иммунологической или пищевой предрасположенностью к заболеванию». [9]
Эта реакция гиперчувствительности приводит к воспалению околоконного эпителия, которое приводит к повышению фибробластической активности и снижению разрушения волокон. Фибробласты фенотипически модифицированы, а формируемые ими волокна более стабильны, образуют более толстые пучки, которые постепенно становятся менее эластичными. как только исходная свободно расположенная фиброзная ткань заменяется продолжающимся фиброзом, подвижность тканей ротовой полости снижается, происходит потеря гибкости и уменьшается открывание рта.
Эти коллагеновые волокна не разлагаются, и фагоцитарная активность сведена к минимуму.
Согласно недавнему перекрестному исследованию, время, необходимое для восстановления pH слюны до исходного уровня после жевания смесей, содержащих орех арека, значительно больше у обычных пользователей OSF по сравнению с теми, кто не пострадал. [9] Sharma et al. Приравняли патогенез OSF к чрезмерному заживлению раны, чтобы объяснить его эволюцию, а также злокачественную трансформацию. [10] [11]
Диагностика
Классификация
Подслизистый фиброз полости рта клинически делится на три стадии: [12]
- 1 стадия: стоматит
- 2 стадия: фиброз
- а- Ранние поражения, побледнение слизистой оболочки рта
- б- Более старые поражения, вертикальные и круговые пальпируемые фиброзные полосы во рту или губах и вокруг них, в результате чего слизистая оболочка щек становится пятнистой, похожей на мрамор.
- а- Лейкоплакия
- б- Нарушения речи и слуха
Ханна и Андраде в 1995 г. разработала систему групповой классификации хирургического лечения тризма: [13]
- Группа I: Самая ранняя стадия без ограничений открывания рта с межрезцовым расстоянием более 35 мм.
- Группа II: пациенты с межрезцовым расстоянием 26–35 мм.
- Группа III: Умеренно запущенные случаи с межрезцовым расстоянием 15–26 мм. На мягком небе видны фиброзные полосы, имеется крыловидно-нижнечелюстной шов и передние столбы зева.
- Группа IVA: тризм тяжелой степени, с межзубным расстоянием менее 15 мм и обширным фиброзом всей слизистой оболочки полости рта.
- Группа IVB: заболевание является наиболее запущенным, с предраковыми и злокачественными изменениями по всей слизистой оболочке. Фактор некроза опухоли альфа и кератин 17.
взаимозависимые регуляторы, они могут быть использованы в качестве диагностических факторов и прогностического зеркала для случаев подслизистого фиброза [14]
Скрининг биопсии, хотя и не является обязательным, большинство стоматологов может визуально осмотреть область и продолжить правильный курс лечения.
- Воздержание от жевания орех ареки (также известный как орех бетель) и табак
- Сведение к минимуму употребления острой пищи, в том числе чили
- Поддержание надлежащего гигиена полости рта
- Дополнение рациона продуктами, богатыми витаминами А, B комплекс, и C и утюг
- Отказ от горячих жидкостей, таких как чай, кофе
- Отказ от алкоголя
- Использование хирурга-стоматолога для округления острых зубов и удаления третьих моляров
- Межпрофессиональный подход к лечению [15]
В лечение также входит следующее:
- Рецепт жевательных гранул гидрокортизон (Эфкорлин); одна гранула, которую нужно жевать каждые три-четыре часа в течение трех-четырех недель
- 0,5 мл внутрь очага поражения Гиалуронидаза 1500 МЕ смешать с 1 мл Лигнокаин в каждую слизистую оболочку щеки один раз в неделю в течение 4 недель или более в зависимости от состояния
- 0,5 мл внутриочаговой инъекции гиалуронидазы 1500 МЕ и 0,5 мл инъекции Гидрокортизон ацетат 25 мг / мл в каждую слизистую оболочку щеки один раз в неделю или в течение 4 недель или более в зависимости от состояния [16]
- Подслизистые инъекции гидрокортизона 100 мг один или два раза в день в зависимости от тяжести заболевания в течение двух-трех недель.
- Подслизистые инъекции человека хорионические гонадотропины (Плацентракс) 2-3 мл на сеанс дважды или трижды в неделю в течение трех-четырех недель
- Хирургическое лечение рекомендуется в случаях прогрессирующего фиброза, когда расстояние между резцами становится менее 2 сантиметров (0,79 дюйма). (Множественные разрезы для высвобождения глубоко в слизистую, подслизистую и фиброзную ткань и ушивание расхождение так создается трансплантатом слизистой оболочки языка и Z-пластика. В этой процедуре на фиброзной ткани делают несколько глубоких z-образных разрезов, а затем зашитый более прямым образом.)
- Пентоксифиллин (Трентал), производное метилксантина, которое обладает сосудорасширяющими свойствами и увеличивает кровоснабжение слизистой оболочки, также рекомендуется в качестве дополнительной терапии при рутинном лечении подслизистого фиброза полости рта. [17]
- IFN-гамма - это антифибротический цитокин, который изменяет синтез коллагена и помогает в OSF. [18]
- Колхицин в таблетках по 0,5 мг 2 раза в сутки [19] , 16 мг в день помогает улучшить OSF [20]
Лечение пациентов с субмукозным фиброзом полости рта зависит от степени клинического поражения. [21] Если болезнь обнаружена на очень ранней стадии, достаточно отказа от привычки. Большинство пациентов с подслизистым фиброзом полости рта имеют заболевание средней и тяжелой степени. Тяжелый субмукозный фиброз полости рта необратим. Умеренный субмукозный фиброз полости рта обратим при прекращении привычки и упражнениях на открывание рта. Современные медицинские методы лечения могут сделать открывание рта до нормального минимального уровня 30 мм при правильном лечении.
Исследование
Недавно ученые доказали, что инъекция внутрь очага поражения аутологичный Стволовые клетки костного мозга - безопасный и эффективный метод лечения фиброза слизистой оболочки полости рта. Было показано, что инъекции аутологичных стволовых клеток костного мозга вызывают ангиогенез в области поражения, что, в свою очередь, уменьшает степень фиброза, что приводит к значительному увеличению открывания рта. [22] [23]
История
В 1952 году Т. Шейх ввел термин distrophica idiopathica слизистой оболочки рта описать устный фиброзное заболевание он обнаружил у пяти индийских женщин из Кения. [24] В 1953 году С.Г. Джоши впоследствии ввел в оборот термин «подслизистый фиброз полости рта» (OSF) для этого состояния. [25]
Волосатая лейкоплакия. Эритроплакия. Гемангиома. Саркома Капоши.
Волосатая лейкоплакия. Эритроплакия. Гемангиома. Саркома Капоши.
Волосатая лейкоплакия представлена нитевидными или плоскими образованиями белого цвета на латеральной поверхности языка, часто с двух сторон, иногда на слизистой щеки. Течение бессимптомное. В 80 % случаев поражение развивается у лиц с синдромом приобретенного иммунодефицита.
Лечение обычно не требуется. При выраженных состояниях местно применяются стероиды в сочетании с антигрибковыми препаратами. Важно ликвидировать беспокойство пациента, убедив его в доброкачественности заболевания.
Эритроплакия
Эритроплакия проявляется в виде бессимптомных красных "вельветовых" пятен. Обнаруживается обычно на дне полости рта и в ретромолярной области у пожилых людей и стариков. Могут быть также участки белого гиперкератоза. Эритроплакия в 90 % случаев превращается в рак. Лечение хирургическое.
![эритроплакия]()
Гемангиома
Гемангиома — доброкачественное образование из кровеносных сосудов наследственной природы. Различают простую, или капиллярную, и кавернозную, или пещеристую, гемангиому. Простая гемангиома имеет вид красного или голубоватого пятна, которое при надавливании теряет свою окраску. Возможны сопутствующие поражения козки. Кавернозная гемангиома состоит из нескольких неодинаковой величины полостей, наполненных венозной кровью и связанных одна с другой анастомозами и соединительнотканными перегородками. Разрастаясь, гемангиомы занимают обширные участки мягких тканей лица, полости рта, языка и др.
Саркома Капоши
Саркома Капоши может возникать на слизистой полости рта как в сочетании с изменениями на коже, так и без них. Высыпания на слизистой полости рта могут быть и первыми проявлениями болезни. Наиболее частая локализация высыпаний при саркоме Капоши — твердое и мягкое небо, резке они возникают на губах и на языке. Появляется опухолевидный узел размером от вишневой косточки до сливы, розовато-коричневого цвета, тестовидной консистенции, на поверхности которого и рядом с ним располагаются петехиальные элементы. Некоторые поражения могут сопровождаться изъязвлениями. Начальные проявления в виде красных, синеватых, фиолетовых пятен причиняют меньше беспокойства больным и обнаруживаются не сразу. Это заболевание часто выявляется у больных СПИДом. Решающее значение в диагностике имеют результаты гистологического исследования.
При саркоме Капоши в полости рта показаны радиационная терапия и хирургическое лечение.Болезни языка
На языке могут локализоваться поражения при травмах, инфекционных заболеваниях, аллергических состояниях, авитаминозах, дерматозах и т. д.
В данном разделе приводятся сведения о складчатом языке и самостоятельных глосситах, т. е. таких процессах, которые встречаются почти исключительно на языке. К ним относят десквамативный глоссит, ромбовидный глоссит, черный (волосатый) язык, складчатый язык.Информация на сайте подлежит консультации лечащим врачом и не заменяет очной консультации с ним.
См. подробнее в пользовательском соглашении.Волосатая лейкоплакия. Эритроплакия. Гемангиома. Саркома Капоши.
Лейкоплакия идиопатическая
Лейкоплакия идиопатическая обычно не вызывает субъективных ощущений и обнаруживается случайно. При обследовании выявляются очаги ороговения различных формы и величины, не возвышающиеся над уровнем слизистой окружающих участков, но с четкими границами поражения. Очаги напоминают белый налет, который, однако, не снимается даже при интенсивном поскабливании.
Наиболее часто лейкоплакия локализуется на слизистой щек и в углах рта, по линии смыкания зубов,
При благоприятных условиях лейкоплакия в течение длительного времени может не причинять беспокойств. Она может не прогрессировать и не превращаться в более выраженные формы заболевания, но может и озлокачествляться.
Клинические признаки озлокачествления: усиление процесса ороговения на спокойном до этого участке, быстрое увеличение размеров и плотности очага; появление уплотнения в основании эрозий, сосочковых разрастаний на поверхности эрозий, кровоточивости при травме. Ранние стадии озлокачествления обычно незаметны (нужно цитогистологическое исследование).
Лейкодема
Лейкодема наблюдается у большинства населения. Поэтому клиницисты рассматривают ее как норму. Чаще встречается у темнокожего населения. Точные причины возникновения не установлены.
Лейкодема обнаруживается случайно при осмотре: отмечается однородное помутнение слизистой щек симметрично с обеих сторон в виде диффузных молочных поверхностей. В выраженных случаях наблюдается изменение слизистой наподобие морщинистой складчатой поверхности. При разглаживании этой опаловой слизистой морщинки исчезают, но мутная поверхность, похожая на налет, остается. Больных лейкодема не беспокоит. Течение длительное. При лейкодеме лечение не требуется. Опасности перехода ее в лейкоплакию и злокачественные опухоли не существует. Важно распознать это состояние и не вмешиваться.
Никотиновый стоматит
Никотиновый стоматит — это кератоз, вызываемый табаком. Обычно связан с интенсивным курением трубки или сигары. Может возникать также у любителей очень горячих пищи и налитков.
Никотиновый стоматит проявляется бессимптомным обширным помутнением слизистой оболочки твердого и мягкого неба с красными точками, соответствующими выводным протокам мелких слюнных желез. Отмечается постепенный переход к нормальному цвету слизистой оболочки без четких границ. Встречается часто, но озлокачествляется очень редко.
Лечение должно быть направлено на устранение курения, после чего возможно быстрое обратное развитие.
Волосатая лейкоплакия
Волосатая лейкоплакия представлена нитевидными или плоскими образованиями белого цвета на латеральной поверхности языка, часто с двух сторон, иногда на слизистой щеки. Течение бессимптомное. В 80 % случаев поражение развивается у лиц с синдромом приобретенного иммунодефицита.
Лечение обычно не требуется. При выраженных состояниях местно применяются стероиды в сочетании с антигрибковыми препаратами. Важно ликвидировать беспокойство пациента, убедив его в доброкачественности заболевания.
Эритроплакия
Эритроплакия проявляется в виде бессимптомных красных "вельветовых” пятен. Обнаруживается обычно на дне полости рта и в ретромолярной области у пожилых людей и стариков. Могут быть также участки белого гиперкератоза. Эритроплакия в 80 % случаев превращается в рак. Лечение хирургическое.
Гемангиома
Гемангиома — доброкачественное образование из кровеносных сосудов наследственной природы. Различают простую, или капиллярную, и кавернозную, или пещеристую, гемангиому. Простая гемангиома имеет вид красного или голубоватого пятна, которое при надавливании теряет свою окраску. Возможны сопутствующие поражения кожи. Кавернозная гемангиома состоит из нескольких неодинаковой величины полостей, наполненных венозной кровью и связанных одна с другой анастомозами и соединительнотканными перегородками. Разрастаясь, гемангиомы занимают обширные участки мягких тканей лица, полости рта, языка и др.
Саркома Калоши
Саркома Капоши может возникать на слизистой полости рта как в сочетании с изменениями на коже, так и без них. Высыпания на слизистой полости рта могут быть и первыми проявлениями болезни. Наиболее частая локализация высыпаний при саркоме Капоши — твердое и мягкое небо, реже они возникают на губах и на языке. Появляется опухолевидный узел размером от вишневой косточки до сливы, розовато-коричневого цвета, тестовидной консистенции, на поверхности которого и рядом с ним располагаются петехиаль- ные элементы. Некоторые поражения могут сопровождаться изъязвлениями. Начальные проявления в виде красных, синеватых, фиолетовых пятен причиняют меньше беспокойства больным и обнаруживаются не сразу. Это заболевание часто выявляется у больных СПИДом. Решающее значение в диагностике имеют результаты гистологического исследования.
При саркоме Капоши в полости рта показаны радиационная терапия и хирургическое лечение.
БОЛЕЗНИ ЯЗЫКА
На языке могут локализоваться поражения при травмах, инфекционных заболеваниях, аллергических состояниях, авитаминозах, дерматозах и т. д.
В данном разделе приводятся сведения о складчатом языке и самостоятельных глосситах, т. е. таких процессах, которые встречаются почти исключительно на языке. К ним относят десквамативный глоссит, ромбовидный глоссит, черный (волосатый) язык, складчатый язык.
Десквамативный глоссит
Глоссит — это воспаление слизистой оболочки языка.
Десквамативный (географический) глоссит характеризуется появлением участков десквамации эпителия нитевидных сосочков, по периферии которых имеются полосы ороговевшего эпителия. В участке десквамации хорошо видны грибовидные сосочки в виде ярко- красных точек. Очаги десквамации обычно множественные, чаще располагаются на кончике и боковой поверхности языка. Вслед за десквамацией происходит ороговение эпителия нитевидных сосочков, а в участках ороговения, наоборот, десквамация. В результате этого участки десквамации и ороговения эпителия нитевидных сосочков языка, сменяя друг друга, мигрируют по поверхности языка и, сливаясь, образуют фигуры, которые напоминают географическую карту.
Субъективно могут появляться боль, чувство жжения, усиливающиеся при употреблении острой, соленой и кислой пищи. Заболевание может длиться неопределенно долго, не причиняя большого беспокойства, иногда спонтанно исчезая на какой-то срок и снова
ПОЯВЛЯЯСЬ •
При отсутствии субъективных ощущений лечение не проводится. При болях и жжении рекомендуются, помимо санации полости рта, полоскания антисептическими растворами, аппликации кератопластических средств. В случае выраженной болезненности целесообразно назначать местные обезболивающие средства.
Срединный ромбовидный глоссит
Срединный ромбовидный глоссит — хроническое заболевание, когда на спинке языка, ближе к корню по средней линии, появляется овальный ромбовидный участок, лишенный сосочков. Различают три формы глоссита: гладкую, бугристую и папилломатозную.
При гладкой форме ромбовидного глоссита поверхность поражения имеет небольшие размеры, розовый или красный цвет, четко отграничена от остальных участков.
В случае бугристой или папилломатозной формы в центре измененного участка есть разрастания, возвышающиеся над уровнем эпителия. Могут появляться участки ороговения белесоватого цвета. Жалоб может не быть. Иногда возникают жжение, пощипывание, усиливающиеся при приеме пищи.
Лечение состоит в санации полости рта, прекращении курения. При значительных папилломатозных разрастаниях их иссекают с последующим патогистологическим исследованием. При отсутствии жалоб, кроме санации полости рта и разъяснения прогноза заболевания, лечения не требуется. Необходимо диспансерное наблюдение.
Волосатый язык
Волосатый язык выражается в разрастании и ороговении нитевидных сосочков средней и задней третей языка. Жалоб может не быть. Чаще больные отмечают необычный вид языка, иногда ощущение инородного тела на нем или рвотный рефлекс, чувство зуда.
На спинке языка кпереди от желобоватых сосочков нитевидные сосочки удлиняются и приобретают светло-коричневый или черный цвет. Длина сосочков иногда достигает 2 см, диаметр до 2 мм, внешне они напоминают волосы. Следует проводить дифференциальную диагностику с пищевой пигментацией сосочков языка, при которой нитевидные сосочки не гиперплазированы.
Лечение заключается в санации полости рта. Местное применение кератолитических средств (3 % раствор резорцина) дает кратковременный эффект. Лучшие результаты получены при проведении криотерапии.
Складчатый язык
Складчатый язык — врожденная аномалия формы и размеров языка, выражающаяся в наличии глубоких борозд (складок), проходящих в различных направлениях. Складки располагаются преимущественно симметрично. Наиболее глубокая продольная складка обычно проходит по срединной борозде. Наличие многочисленных складок создает картину деления языка на множество долек. Сосочки хорошо выражены, иногда гипертрофированы. Складчатый язык нередко сочетается с очаговой десквамацией эпителия языка. Наличие глубоких складок благоприятствует вегетации грибковой микрофлоры. При недостаточном уходе за полостью рта может развиться воспалительный процесс, возникают жжение и боль.
Местное лечение при складчатом языке не проводится. Необходимы тщательный уход за полостью рта, своевременная санация.1. Гломерулонефрит
![]()
Почка малокровная, бледная с желтым крапом. При электронно-микроскопическом исследовании выявляется отсутствие малых отростков подоцитов. Название заболевание?
1. липоидный нефроз
2. мембранозная нефропатия
3. амилоидный нефроз
4) 15_s025 фото ИИ
![]()
В почке обнаружено отложение гомогенных масс амилоида розового цвета. Укажите исход заболевания.
1. первичное сморщивание
2. вторичное сморщивание
3. интерстициальный нефрит
5) 15_b004 из темы 8
![]()
У больного перед смертью развились олигурия и азотемия. На вскрытии обнаружены уменьшенные и сморщенные почки, дифтеритический колит. Назовите развившееся осложнение, послужившее причиной смерти.
1. сердечная недостаточность
3. некротический нефроз
6) 15_b022 из темы 8
![]()
Больной скончался. На вскрытии поставлен диагноз уремия. Какие изменения во внутренних органах позволяют сделать такое заключение?
1. камни мочеточников
2. фибринозный перикардит
3. митральный стеноз
![]()
Некроз эпителия извитых канальцев, ядра отсутствуют, цитоплазма гомогенная, эозинофильная, набухшая. Просветы канальцев сужены. Клубочки и прямые канальцы не изменены. Описанные изменения являются проявлением некротического нефроза. Укажите возможную причину смерти.
1. инфаркт миокарда
8) 15_b145 из темы 7
Мочевой пузырь увеличен: его стенки и трабекулы утолщены, полость расширена. Предстательная железа увеличена, плотная, бугристая, сдавливает мочеиспускательный канал. Каким заболеванием почек может осложниться подобное состояние?
3. вторично-сморщенной почкой
4. ничем из перечисленного
![]()
Заболевание часто развивается через 2-3 нед. после стрептококковой ангины. Почка при этом несколько увеличена, набухшая, бледная, с мелким красным крапом на поверхности -«большие пестрые почки». Прогноз благоприятный. Назовите заболевание.
1. острый гломерулонефрит
2. подострый гломерулонефрит
3. хронический гломерулонефрит
![]()
В расширенной лоханке видны коралловидные камни желтого цвета – ураты. Назовите возможное осложнение.
1. Пиелонефрит
3. все перечисленное
4. ничего из перечисленного
![]()
У больного вокруг пупка видны расширенные вены. Через некоторое время больной скончался. На вскрытии: печень деформирована, уплотненена, уменьшена в размерах, поверхность зернистая. На разрезе видны крупные и мелкие узелки печеночной ткани различных размеров, окруженные кольцом соединительной ткани - дайте название описанным структурам; поставьте диагноз, назовите внепеченочные изменения.
1. билиарный цирроз печени, тельца Каунсильмена; «голова медузы»
2. портальный цирроз печени, «ложные» дольки; коллатеральная гиперемия вен передней брюшной стенки
3. портальный цирроз печени, тельца Маллори; « голова медузы»
![]()
Печень плотной консистенции, бугристая, на разрезе с очагами желтого цвета и ложными дольками. Назовите заболевание. Что такое «ложная долька»?
1. цирроз печени; дольки, образованные гепатоцитами в состоянии коагуляционного некроза
2. цирроз печени; дольки, образованные фибриллярным белком, синтезируемым гепатоцитами, обнаруживается в цитоплазме гепатоцитов и экстрацеллюлярно
3. цирроз печени; дольки, в которых нет центральной вены, или она расположена эксцентрично, или таких вен несколько
3) 16_s099 стрелки
![]()
Разрастание соединительной ткани по ходу портальных трактов в виде колец с образованием так называемых «ложных долек». О каком патологическом процессе в печени идет речь?
4) 16_ l02. стрелки
![]()
Обнаружение гепатоцитов в состоянии коагуляционного некроза (указаны стрелкой), характерно для вирусного гепатита. Как иначе называются эти гепатоциты?
1. тельца Маллори
2. тельца Русселя
3. тельца Каунсильмена
![]()
Данное заболевание развивается вследствие массивного некроза печеночной ткани, коллапса стромы и разрастания соединительной ткани в виде широких полей; образуются мультилобулярные ложные дольки, сближающие портальные тракты; поверхность печени бугристая. Назовите заболевание.
1. билиарный цирроз печени
2. постнекротический цирроз печени
3. портальный цирроз печени
![]()
Данное заболевание - результат подпеченочной желтухи: вызван обструкцией внепеченочных желчных протоков, характеризуется холестазом в центрах долек, пролиферацией эпителия желчных протоков, холангитом. Макроскопически печень темно-зеленая, мелкоузловая. Назовите заболевание.
1. билиарный цирроз печени
2. постнекротический цирроз печени
3. портальный цирроз печени
![]()
Проявлением гепато-лиенального синдрома является увеличенная в размерах селезенка (масса более 500 г), на капсуле матовые полупрозрачные очаги. Как называется такое состояние?
1. порфировая селезенка
2. сальная селезенка
3. септическая селезенка
![]()
В дистальном отделе толстой кишки варикозно расширенные вены бурого цвета. Проявлением какого синдрома при циррозе печени является данное состояние?
1. печеночно-клеточной недостаточности
2. астенического синдрома
3. синдрома портальной гипертензии
![]()
Как называют печеночные дольки, в которых нет центральной вены, или она расположена эксцентрично, или таких вен несколько?
На разрезе печень однородная, желтого цвета. Как называется такая печень?
1. мускатная печень
2. «глазурная» печень
3. «кремневая» печень
4. «гусиная» печень
![]()
На слизистой оболочке желудка и 12-перстной кишки видны 3 язвенных дефекта. В желудке язва удлиненной формы с подрытыми плотными краями и плотным дном. В 12-перстной кишке 2 язвы округлой формы, расположенные друг против друга, одна из них – с осложнением. Описанные макроскопические признаки говорят об остром или хроническом процессе? Приведите критерии.
1. острая язва желудка: удлиненная форма, плотные подрытые края, плотное дно
2. хроническая язва желудка: захватывает толщу слизистой оболочки, не имеет склеротических изменений в дне и на краях
3. хроническая язва желудка: проникает за пределы слизистой в толщу стенки желудка, имеет грубые фиброзные изменения в дне и валикообразные приподнятые края; проксимальный край язвы подрытый
![]()
На слизистой оболочке желудка множественные поверхностные дефекты слизистой с ровными краями, дно черного цвета. Поставьте диагноз, назовите пигмент.
1. хронические язвы желудка; солянокислый гематин
2. рак желудка; гемосидерин
3. эрозии слизистой желудка; солянокислый гематин
![]()
На малой кривизне желудка виден язвенный дефект круглой формы до 1 см в диаметре, дно и края плотные, валикообразные. Назовите заболевание.
1. хроническая язва желудка
2. острая язва желудка
3. эрозии желудка
![]()
Толстая кишка на разрезе. Слизистая оболочка толстой кишки пропитана кровью черного цвета. Осложнением какого заболевания может быть данное состояние?
1. геморрагический колит
2. язвенная болезнь
3. полип толстой кишки
4. болезнь Крона
5) 17_ s062 стрелки
![]()
В дне хронической язвы различают 4 слоя:
1) зона некроза с лейкоцитами, 2) фибриноидный некроз, 3) зона грануляционной ткани, 4) зона склероза. Укажите расположение описанных зон на микрофотографии.
![]()
Все слои червеобразного отростка инфильтрированы лейкоцитами, слизистая оболочка изъязвлена. В подслизистой оболочке полнокровные сосуды и кровоизлияния. Определите тип экссудативного воспаления в данном органе.
![]()
Укажите ретроградный лимфогенный метастаз при раке желудка.
1. опухоль Уортина
2. крукенбергский рак яичников
3. метастазы в печень
![]()
Укажите ретроградные лимфогенные метастазы при раке желудка.
1. метастазы в печень
2. карциноматоз легких
3. метастаз Шнитцлера
![]()
Метастаз Вирхова при раке желудка локализуется в
1. лимфатические узлы параректальной клетчатки
2. левые надключичные лимфатические узлы
![]()
Метастаз Шнитцлера при раке желудка локализуется:
1. лимфатические узлы параректальной клетчатки
2. левые надключичные лимфатические узлы
![]()
В средней части пищевода образование размерами 5х4 см, границы нечеткие, в центре некроз с перфоративным отверстием. Поставьте диагноз, укажите преимущественный путь метастазирования.
1. пищевод Баррета; лимфогенный
2. рак пищевода; лимфогенный
3. ботриомикома; не метастазирует
![]()
Выше бифуркации трахеи на слизистой оболочке располагается белесоватое образование, которое, охватывая трахею циркулярно, суживает ее просвет. Какой тип роста у описанного новообразования?
3. ничего из перечисленного
4. все перечисленное
![]()
Из бронха в области корня легкого исходит белесоватая плотная опухоль, прорастающая стенку бронха, образующая опухолевый узел до 8 см в диаметре. Диагноз?
2. периферический рак легкого
3. центральный рак легкого
![]()
На вскрытии обнаружено: стенка желудка утолщена, белесоватая, плотная, складки сглажены. Предположительный диагноз?
1. аденокарцинома желудка
2. скирр желудка
3. фунгозный рак желудка
![]()
В верхней части желудка стенка утолщена, белесоватого цвета. Опухоль прорастает всю стенку желудка. Что это за опухоль?
1. аденокарцинома желудка
2. скирр желудка
3. фунгозный рак желудка
![]()
В верхней части желудка опухоль в виде узла, 7 см в диаметре, с экзофитным ростом, опухоль на разрезе бело-серая, плотной консистенции, на широком основании. Определите опухоль.
1. аденокарцинома желудка
2. скирр желудка
3. фунгозный рак желудка
![]()
Новообразование сосочкового строения, имеет вид «цветной капусты». Выберите соответствующую микроскопическую картину.
1. паренхима и строма опухоли развиты равномерно; паренхима представлена атипичными железами различно формы и величины; анаплазированный эпителий желез пролиферирует, образуя сосочки, местами он прорастает за пределы базальных мембран желез.
2. соединительнотканные сосочки опухоли покрыты многослойным плоским эпителием; количество слоев клеток в эпителии в разных участках опухоли различно; эпителий не прорастает базальную мембрану.
8) 10_s217а или из лекции
![]()
Гнездные скопления опухолевых клеток с выраженным клеточным атипизмом и очагами ороговения. Как иначе называют эти очаги ороговения.
1. «раковые жемчужины»
9) 10_s071 + макро
![]()
![]()
Местнодеструирующая опухоль кожи лица. Под покровным эпителием кожи видны тяжи и комплексы мелких гиперхромных клеток, проникающих в дерму (инфильтрирующий рост). Поставьте диагноз.
![]()
![]()
Макроскопически: эпителиальное новообразование сосочкового строения, имеет вид “цветной капусты”. Сделайте заключение.
Волосатая лейкоплакия
![волосатая лейкоплакия]()
Волосатая лейкоплакия – это болезнь, развивающаяся на слизистой оболочке ротовой полости. Она вызывается вирусом Эпштейна-Барра. Зачастую лейкоплакия сопровождает тяжелые хронические заболевания, которые оказывают сильное угнетающее воздействие на иммунитет – например, ВИЧ или острый лейкоз. Наиболее типичными признаками волосатой лейкоплакии являются белёсые бляшки, формирующие шероховатые складки на щеках и языке.
Причины возникновения
Общая наиболее значимая причина возникновения лейкоплакии – серьезное снижение иммунитета в сочетании с хроническими механическими повреждениями языка – например, о края неровных зубов, неправильно установленные зубные импланты, коронки или брекеты.
Снижение иммунитета, вызывающее волосатую лейкоплакию, бывает зачастую спровоцировано вирусом иммунодефицита, приемом иммуносупрессивных препаратов, а также такими заболеваниями, как красная волчанка, ревматоидный артрит и/или склеродермия.
Важно также помнить, что одним из провоцирующих факторов для возникновения волосатой лейкоплакии является курение.
Заболевание вызывается вирусом, который присутствует в организм 90% населения планеты. Разница только в том, что здоровый организм подавляет развитие вируса с помощью Т-лимфоцитов. Если же организм поражен заболеванием, при котором концентрация Т-лимфоцитов снижается, иммунитет перестает справляться, делая человека уязвимым для инфекций.
Симптомы заболевания
Основной опасностью волосатой лейкоплакии является то, что она достаточно долго может никак не проявляться, и только посещение стоматолога может помочь вовремя выявить это заболевание. Первый и самый типичный симптом, который должен вас насторожить – это сильный налёт белого или серого цвета, покрывающий спинку и нижнюю часть языка.
Как правило, страдающие лейкоплакией не чувствуют особенного дискомфорта – разве что в тех случаях, когда болезнь сопровождается грибком.
Для данного заболевания характерны следующий признаки:
- Появление складок и бляшек, образованных из налёта;
- Трещины на языке;
- Эрозии в запущенной стадии заболевания;
- Общие признаки иммунодефицита: диарея, резкое похудание, ночная потливость, возникающие без видимых причин лихорадки, общая болезненность и слабость.
Диагностика заболевания
Диагностика лейкоплакии проводится врачом-стоматологом. Для точной постановки диагноза необходимо использовать лабораторные и инструментальные исследования. Наиболее важным этапом диагностики является проведение биопсии очага поражения и последующий гистологический анализ.
Очень важно провести лабораторную диагностику ВИЧ, а также перед постановкой диагноза «волосатая лейкоплакия» исключить такие заболевания, как кандидоз полости рта, кондилома, гипертрофия сосочков рта, остроконечные кондиломы и кератоз слизистой оболочки.
Лечение волосатой лейкоплакии
Поскольку в большинстве случаев заболевание возникает у людей с ВИЧ, необходимой мерой является антиретровирусная терапия, а также специальная иммунотерапия с применением противовирусных препаратов.
Для местного лечения применяют препараты, содержащие в себе ретиноевую кислоту и препараты кератолитического типа. В случаях, если болезнь прогрессирует и находится в тяжелой для излечения стадии, показано хирургическое вмешательство: пораженные участки языка и слизистой оболочки рта иссекают лазером.
Вне зависимости от того, насколько тяжела стадия волосатой лейкоплакии, пациенту придется отказаться от курения и с осторожностью употреблять пищу, которая может травмировать поврежденную слизистую оболочку рта – то есть слишком горячую, острую или твёрдую.
Волосатая лейкоплакия – это заболевание, склонное к рецидивам, поэтому даже после завершения лечения рекомендуется регулярно посещать стоматолога.
2019 © Хорошая стоматология — сеть стоматологических клиник.
Стоматологические услуги около м. Верхние Лихоборы, м. Митино, м. Тушинская, м. Речной вокзал, м. Отрадное, м. ЩелковскаяДанная страница носит информационно-справочный характер и не является публичной офертой.
Читайте также: